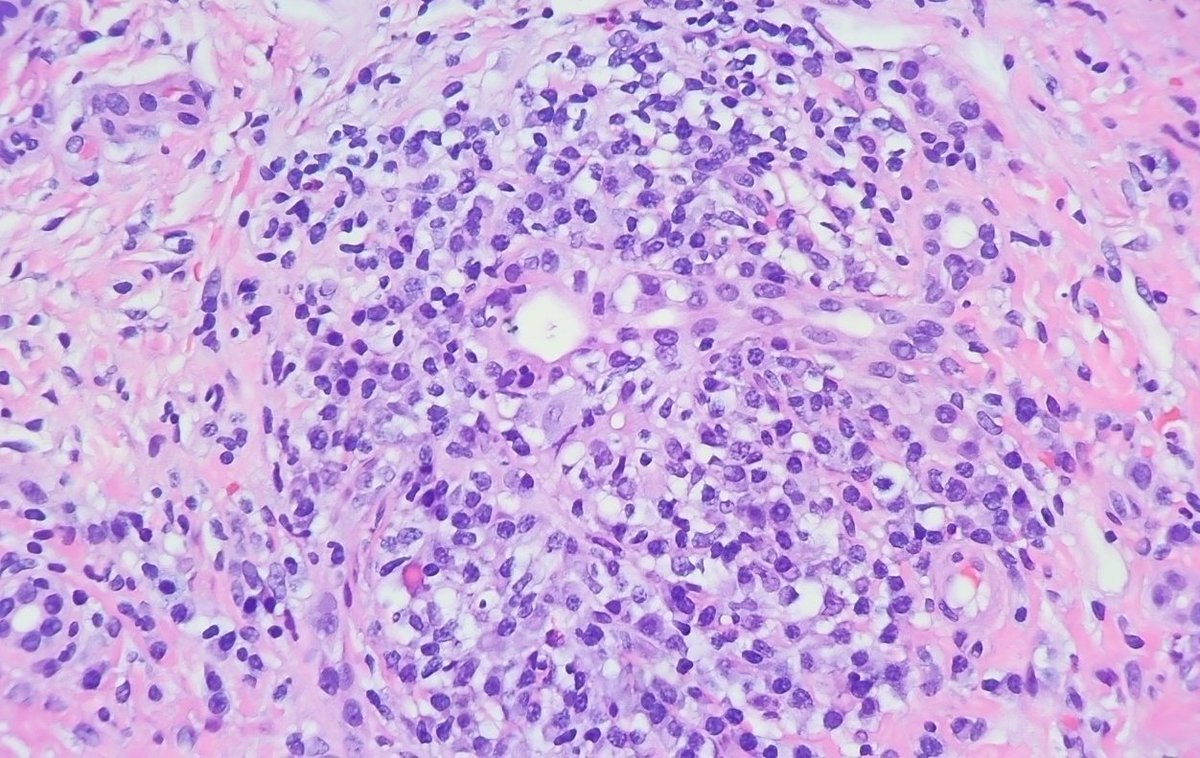
Tell us your thoughts 💭🧐

#pathology #GIpath #pathresidents

Purva Gopal
@purvago
GI and Liver pathologist at UT Southwestern Medical Center @UTSW_GIpath #girlmom
ID: 605967221
https://utswmed.org/doctors/purva-gopal/ 12-06-2012 03:14:36
681 Tweet
1,1K Followers
446 Following





Variations of P40 and P63 #IHC in Different Grades of Esophageal Squamous Cell Ca: A Potential Diagnostic Pitfall ❗️ - P40 and P63 expression lower in well-diff SCC compared to higher grade #GIpath #IHCpath journals.lww.com/appliedimmunoh… Purva Gopal Suntrea Hammer UTSW GI Pathology








Join us! Check out the GIPS (GI Pathology Society) @The_USCAP Palm Springs microscopy course "Reaching the Diagnosis in Difficult Cases" w/ Raul Gonzalez (Raul S. Gonzalez, MD), Laura Tang, Namrata Setia (nsetia), Purva Gopal (@purvago). Nov 6-8, 2024. shorturl.at/tyEO4 #GIpath #PathTwitter



Thank you Elliot Tapper and Hepatology Communications for the opportunity for us to share a pathology perspective on the continued utility of liver biopsy Xuchen Zhang Xiaobang Hu UTSW GI Pathology UTSW Department of Pathology

Don't miss this great #GIpath interactive microscopy by GIPS (GI Pathology Society) & USCAP! Purva Gopal tinyurl.com/vnrbb2kd


Chair of the education committee, Dr. Rajal B Shah, opens #TSP2025! Texas Society of Pathologists #Pathology UTSW Department of Pathology


Dr. Sunati Sahoo covers the history and future of breast cancer diagnosis and treatment at #TSP2025 UTSW Department of Pathology Texas Society of Pathologists #Pathology



Congratulations to our fantastic graduating fellow, Julia Gallardo, MD. 🎉 🎉 🎉 We are thrilled to announce that Dr. Gallardo will be joining us as our 7th GI/liver fellowship-trained pathologist. #pathology #GIpath #pathX